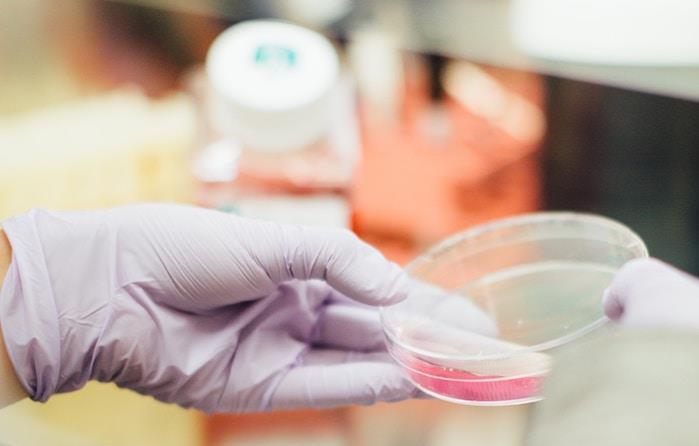

Strategic Investment in Innovation
Orlando Health Ventures is advancing healthcare innovation by strategically investing in early stage companies and technologies that are transforming and disrupting the healthcare industry. Through a collaborative effort with our clinicians and leaders, Orlando Health Ventures sources, evaluates, and invests in innovative companies that demonstrate potential for a strong return on investment, high growth opportunity and that align with the mission of Orlando Health.
Meet the Ventures Team
Portfolio Companies
Portfolio News & Updates

Vesalio announces successful initial use of NeVa VS device in USA
Vesalio successfully deployed it's NeVa VS device in the United States for treatment of post-aneurysmal subarachnoid hemorrhage (aSAH) cerebral vasospasm. WellStart Health System is the first center in the country to use the device. NeVa VS is currently the only FDA approved device for this indication and the only device on the market specifically designed to treat vasospasm.

Study with Vasalio's EnVast Demonstrates Improved Thrombectomy
Dr. Dario Bongiovanni used Vesalio's EnVast as a bailout thrombectomy in no-flow STEMI after conventional thrombus aspiration failure. Histology showed predominantly red clots aspirated by conventional aspiration, whereas EnVast extracted mixed thrombi with a significantly greater prevalence of platelets and connective tissue. Our preliminary findings suggest that EnVast retrieved more complex and extensive thrombotic structures providing an improved thrombectomy.

Orlando Health Ventures Invests in $1.25M Innovative Heart Valve Repair Device
Orlando Health Ventures has invested $1.25 million in Biostable Science & Engineering, an Austin based cardiovascular device company developing heart valve repair technologies that provide an alternative to heart valve replacement for patients. Biostable’s HAART device provides an alternative to mechanical and tissue valve replacement and reshapes and stabilizes the aortic valve to enable a consistent, standardized surgical approach to valve repair, enabling more widespread adoption of the procedure.

Winnie Palmer Hospital Launches New AI Technology to Address Maternal Health Complications
Orlando Health Winnie Palmer Hospital for Women & Babies is the first hospital in Central Florida to implement a new artificial intelligence technology to address preventable health complications during childbirth. TritonTM, a product of Gauss Surgical, monitors blood loss in real time using digital imaging and machine learning on an iPad.